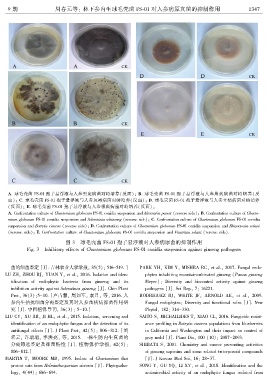

Page 132 - 《广西植物》2020年第9期
P. 132
9 期 周春元等: 林下参内生球毛壳菌 FS ̄01 对人参病原真菌的抑制作用 1 3 4 7
A. 球毛壳菌 FS ̄01 孢子悬浮液与人参黑斑病菌对峙培养(反面)ꎻ B. 球毛壳菌 FS ̄01 孢子悬浮液与人参菌核病菌对峙培养(反
面)ꎻ C. 球毛壳菌 FS ̄01 孢子悬浮液与人参灰霉病菌对峙培养(反面)ꎻ D. 球毛壳菌 FS ̄01 孢子悬浮液与人参立枯病菌对峙培养
(反面)ꎻ E. 球毛壳菌 FS ̄01 孢子悬浮液与人参根腐病菌对峙培养(反面)ꎮ
A. Confrontation culture of Chaetomium globosum FS ̄01 conidia suspension and Alternaria panax (reverse side)ꎻ B. Confrontation culture of Chaeto ̄
mium globosum FS ̄01 conidia suspension and Sclerotinia schinseng (reverse side)ꎻ C. Confrontation culture of Chaetomium globosum FS ̄01 conidia
suspension and Botrytis cinerea (reverse side)ꎻ D. Confrontation culture of Chaetomium globosum FS ̄01 conidia suspension and Rhizoctonia solani
(reverse side)ꎻ E. Confrontation culture of Chaetomium globosum FS ̄01 conidia suspension and Fusarium solani (reverse side).
图 3 球毛壳菌 FS ̄01 孢子悬浮液对人参病原菌的抑制作用
Fig. 3 Inhibitory effects of Chaetomium globosum FS ̄01 conidia suspension against ginseng pathogens
菌的细菌鉴定 [J]. 吉林农业大学学报ꎬ 35(5): 516-519. ] PARK YHꎬ KIM Yꎬ MISHRA RCꎬ et al.ꎬ 2017. Fungal endo ̄
LU ZHꎬ ZHOU RJꎬ YUAN Yꎬ et al.ꎬ 2016. Isolation and iden ̄ phytes inhabiting mountaincultivated ginseng (Panax ginseng
tification of endophytic bacteria from ginseng and its Meyer): Diversity and biocontrol activity against ginseng
inhibition activity against Sclerotinia ginseng [J]. Chin Plant pathogens [J]. Sci Repꎬ 7: 16221.
Protꎬ 36(3):5-10. [卢占慧ꎬ 周如军ꎬ 袁月ꎬ 等ꎬ 2016. 人 RODRIGUEZ RJꎬ WHITE JFꎬ ARNOLD AEꎬ et al.ꎬ 2009.
参内生拮抗细菌分离鉴定及其对人参菌核病抑菌作用研 Fungal endophytes: Diversity and functional roles [J]. New
究 [J]. 中国植保导刊ꎬ 36(3): 5-10.] Phytolꎬ 182: 314-330.
LIU CYꎬ XU RRꎬ JI HLꎬ et al.ꎬ 2015. Isolationꎬ screening and SAITO Sꎬ MICHAILIDES Tꎬ XIAO CLꎬ 2016. Fungicide resist ̄
identification of an endophytic fungus and the detection of its ance profiling in Botrytis cinerea populations from blueberries
antifungal effects [J]. J Plant Protꎬ 42(5): 806-812. [刘 in California and Washington and their impact on control of
彩云ꎬ 许瑞瑞ꎬ 季洪亮ꎬ 等ꎬ 2015. 一株生防内生真菌的 gray mold [J]. Plant Disꎬ 100 (10): 2087-2093.
分离筛选鉴定及抑菌特性 [J]. 植物保护学报ꎬ 42(5): SHIBATA Sꎬ 2001. Chemistry and cancer preventing activities
806-812.] of ginseng saponins and some related triterpenoid compounds
MARTIN Tꎬ MOORE MBꎬ 1995. Isolate of Chaetomium that [J]. J Korean Med Sciꎬ 16: 28-37.
protest oats from Helminthosporium victoria [J]. Phytopatho ̄ SONG Yꎬ GU YQꎬ LI XYꎬ et al.ꎬ 2018. Identification and the
logyꎬ 4(44): 686-694. antimicrobial activity of an endophytic fungus isolated from